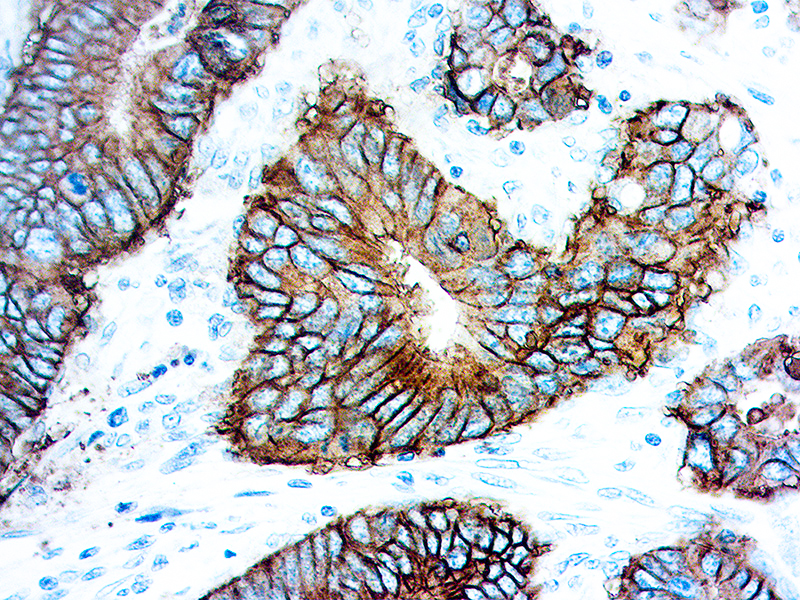

MOC-31 antibody recognizes an epithelial-associated, glycoprotein located on the cell membrane surface and in the cytoplasm of virtually all epithelial cells. It is not present in most squamous epithelia, hepatocytes, renal proximal tubular cells, gastric parietal cells and myoepithelial cells. MOC31 may be used in a panel of antibodies as a negative marker for mesothelioma, or lung adenocarcinoma. Studies have shown that MOC-31 is useful in differentiating tumors of unknown origin in liver cancers and distinguishing cholangiocarcinoma from hepatocellular carcinomas
MOC-31
SKU: Mob546-
Categories: Primary Antibodies, IVD - For U.S. Market, IVD - Outside U.S. Market
Tags: Concentrated, M
Description
Additional information
| Clone | MOC-31 |
|---|---|
| Isotype | IgG1 |
| Immunogen | Tissue, cells or virus corresponding to Human EpCAM. Neuraminidase treated GLS-1 human small cell lung carcinoma cells |
| Species | Mouse |
| Cellular Localization | Cytoplasmic, Epithelial |
| Positive Control Tissue | Colon and Breast(Normal & Carcinomas) |
| Pretreatment | HistoZyme pH 9.0 |
| Incubation & Temperature | 30 min @ RT |
| Intended Use | IVD |
| Detection System | PolyVue Plus – Two Step Detection System or Montage PolyVue Plus Auto Detection System for Montage 360 System |
| Description/Type | Mouse Monoclonal Antibody |
| Format | Buffer with purified IgG protein carrier and preservatives |
DATASHEETS & SDS
DATASHEETS & SDS
| Download Datasheet |
| Download SDS Sheet – OSHA |
REFERENCES
REFERENCES
- Castronovo et al. J Pathol 179: 43, 1996.
- Fernandez et al. J Pathol 181: 80, 1997.
- Gasbarri et al. J Clin Oncol 17: 3494, 1999.
- Kasper et al. J Pathol 179: 309, 1996.
Reviews (0)
Only logged in customers who have purchased this product may leave a review.

Reviews
There are no reviews yet.